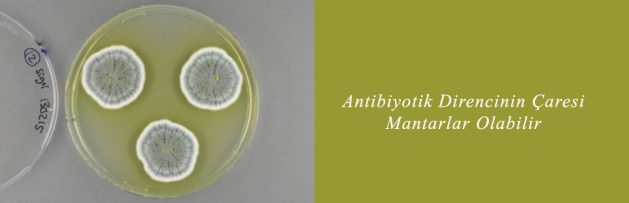

Antibiyotik Direncinin Çaresi Mantarlar Olabilir
Nature Microbiology dergisinde yayımlanan bir çalışmada, İsveç Chalmers Teknoloji Üniversitesinden araştırmacılar, antibiyotiklerden kanser ilaçlarına çeşitli biyoetken maddelerin üretiminde kullanılabilecek Penicillium adlı mantarın 9 farklı türünün genlerini incelediler. Araştırmacılar ilaç üretiminde kullanılabilecek çok sayıda etken maddeyi üretmenin binden fazla yolunu buldular.
Araştırmacılar ayrıca yanuton adlı antibiyotiğin eski ve yeni versiyonlarını üretebilen yeni mantarlar da keşfettiler. Bilim insanlarına göre mantarlar mevcut antibiyotiklerin daha etkili versiyonlarını üretmekte de işe yarıyorlar.
Araştırmacı Jens Christian Nielsen daha önce yeni antibiyotik çalışmalarının bakterilere odaklandığını, yeni çalışmanın daha güçlü ilaçların doğal yollardan üretilmesini sağlayabileceğini belirtiyor. Ayrıca ilaç firmalarının yatırım yapmak istemediği bir alan olan yeni antibiyotik üretimini kolaylaştırabileceğini belirtiyor.
Global analysis of biosynthetic gene clusters reveals vast potential of secondary metabolite production in Penicillium species
Nielsen JC, Grijseels S, Prigent S, et al. Article number: 17044 (2017) doi:10.1038/nmicrobiol.2017.44
Received:Accepted:Published online: